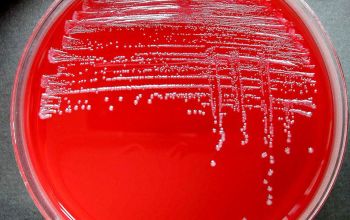
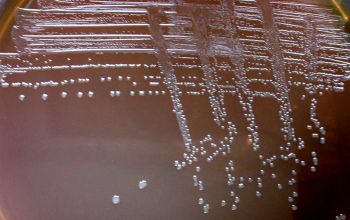

Bacteroides vulgatus (Phocaeicola vulgatus)
-
General information
Bacteroides fragilis group, are the most frequently encountered anaerobes in clinical specimens.
They tend to be more virulent and drug resistant than most other anaerobes.
Therefore it is important to identify members of the B. fragilis group
Of these especially B. fragilis, B. thetaiotaomicron, and B. ovatus are highly relevant in human infections.
Taxonomy
Family: Bacteroidaceae
Genus: Phocaeicola vulgatus
Formely: Bacteroides vulgatus
Natural habitats
They inhabit the mucosal surfaces of the oral cavity, gastrointestinal tract and the gut of animals and human.
Clinical significance
They are involved in a variety of infections associated with considerable morbidity and mortality.
Anaerobic bacteria can occasionally spread to the adjacent tissues and the bloodstream with serious consequences.
In cases when gram negatives anaerobes gain entrance to the bloodstream and trigger a systemic inflammatory response, this may result in a sepsis or infective endocarditis with a fatal outcome.
-
Gram stain
Light colored, short, Gram negative rods,
0.5-0.8 x 1.5-4.5 µm,
with rounded ends, lying alone or in pairs.
B. vulgatus swelling or vacuoles can be seen
Liquid medium:
cells tend to be pleomorphic often with vacuoles
-
Culture characteristics
-
Obligate anaerobic
BBAØ: the colonies are gray, circular, convex and entire
BBEØ: growth with pale colonies > 1 mm and causing browning of the medium as a result of esculin hydrolysis
Fluorescence under long-wave UV light (Woods lamp)
Negative
-
-
Characteristics
-
References
James Versalovic et al.(2011) Manual of Clinical Microbiology 10th Edition
Karen C. Carrol et al (2019) Manual of Clinical Microbiology, 12th Edition